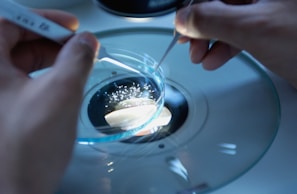
Close-up of hands analyzing soil samples in a laboratory setting.

Análisis inicial
Evaluamos tus necesidades y el contexto ambiental.


Planificación detallada
Diseñamos estrategias personalizadas que cumplen con normativas y objetivos específicos para tu proyecto ambiental.


Ejecución y seguimiento
Implementamos soluciones y monitoreamos resultados para asegurar el cumplimiento y la mejora continua.
Experiencia Profesional
Más de 10 años brindando soluciones ambientales con rigor técnico y compromiso con la normativa vigente.
Trayectoria
Proyectos Destacados
Desde estudios de impacto hasta gestión integral ambiental.


Áreas de Trabajo
Experience. With our intuitive design and user-friendly interface, your website will captivate visitors. 2
Nuestro proceso
Cada paso pensado para cuidar tu proyecto ambiental.